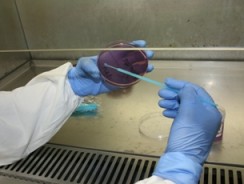

-
.png&w=244&h=184)
Cancer
Cancer is the second leading cause of death among Indigenous people.
-

Child health and development
Our work investigates how we can improve the health of Indigenous children so they can have the best start in life.
-

-

Housing
Housing is a human right and a major contributing factor to human health and wellbeing. Despite significant recent investment, there continues to be an undersupply of social and remote housing in the Northern Territory, with existing housing facing a...
-

-

Mental health and wellbeing
Helping communities and individuals to stay strong.
-
Nutrition
Diet is the leading contributor to the burden of disease for all Australians. Dietary improvement is essential to closing the gap in health, education and life expectancy for Indigenous Australians.
-

Preventative health
A significant proportion of Menzies' work is in disease treatment research, but we also recognise that preventive health measures have an important role to play in improving overall health outcomes.
-

Primary health care and health systems research
An important component of Closing the Gap.
-

-
.jpg&w=244&h=184)
Skin health
Childhood skin infections can have a long-lasting and devastating effect.
-

Smoking, alcohol, drugs and other addictive behaviours
The harm caused by tobacco, alcohol and other drugs is a major public health problem for Indigenous Australians.
-

Youth health
There is little known about Indigenous adolescent lives. Yet, it’s such an extraordinary stage because there’s incredibly rapid development.